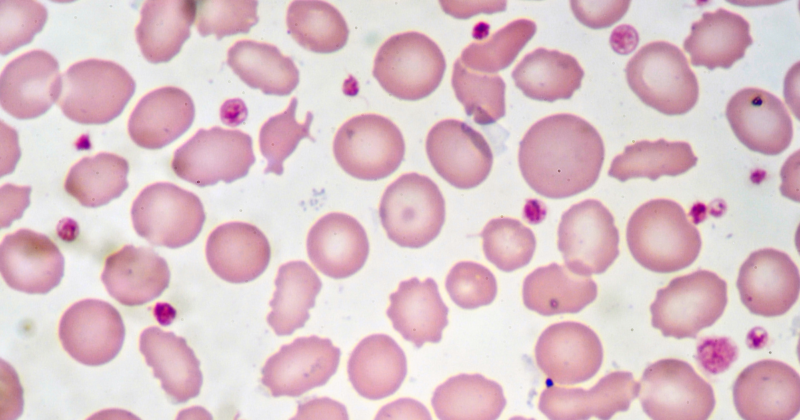
Vitamina B12 e anemia: hemácias observadas em lâmina de sangue

A transferrina, também conhecida como siderofilina, é uma das proteínas mais importantes avaliadas quando existe suspeita de deficiência de ferro, anemia ou alterações no metabolismo do ferro. Esse exame costuma gerar dúvidas porque, muitas vezes, aparece alterado mesmo quando o ferro sérico ou a ferritina parecem “normais”.
Entender o que é a transferrina, quando ela sobe ou cai e como interpretar o índice de saturação da transferrina é fundamental para evitar diagnósticos incompletos e atrasos no tratamento.
Neste conteúdo, você vai aprender exatamente como esse exame funciona, o que significam os resultados e quando é necessário investigar mais a fundo.
O que é transferrina
A transferrina é uma proteína produzida principalmente pelo fígado. Sua função é transportar o ferro pelo sangue, levando esse mineral até a medula óssea, onde ele será utilizado na produção das hemácias (glóbulos vermelhos).
Uma forma simples de entender:
- O ferro é a carga
- A transferrina é o “caminhão” que transporta essa carga
Sem a quantidade suficiente dessa proteína — ou quando ela não funciona adequadamente — o ferro não chega onde deveria, mesmo que exista ferro circulante no organismo.
Para que serve o exame de transferrina
O exame de siderofilina é utilizado para avaliar como o organismo está lidando com o ferro, e não apenas a quantidade isolada desse mineral no sangue.
Ele costuma ser solicitado para:
- Investigar anemia, especialmente quando o hemograma está alterado
- Avaliar deficiência de ferro em fases iniciais
- Diferenciar tipos de anemia
- Monitorar doenças inflamatórias e crônicas
- Avaliar alterações hepáticas
- Complementar a análise de ferro sérico e ferritina
Na prática, esse exame ajuda o médico a entender se o problema está na falta de ferro, no transporte do ferro ou no aproveitamento desse mineral.
Diferença entre transferrina, ferro sérico e ferritina
Esses exames são frequentemente solicitados juntos, mas avaliam coisas diferentes:
- Ferro sérico: quantidade de ferro circulando no sangue naquele momento
- Ferritina: reserva de ferro armazenada no organismo
- Transferrina: capacidade do organismo de transportar o ferro
É possível, por exemplo, ter:
- Ferro sérico normal
- Ferritina normal
- Transferrina alterada
Por isso, analisar apenas um marcador isolado pode levar a interpretações incorretas.
👉Dica de leitura: Ferritina Alta ou Baixa: O Que Significa e Quando se Preocupar
Índice de saturação da transferrina: o que é e por que é tão importante
O índice de saturação da transferrina mostra quanto da transferrina está efetivamente carregada com ferro.
Esse índice é calculado a partir da relação entre:
- Ferro sérico
- Capacidade total de ligação do ferro (transferrina)
Ele é considerado um dos indicadores mais confiáveis para avaliar o metabolismo do ferro.
Valores de referência (podem variar conforme o laboratório):
- Geralmente entre 20% e 50%
Valores fora dessa faixa ajudam a identificar tanto deficiência quanto sobrecarga de ferro.
Índice de saturação da transferrina baixo: o que significa
Quando o índice de saturação está baixo, significa que há pouco ferro disponível para ser transportado, mesmo que a transferrina esteja elevada.
As causas mais comuns incluem:
- Deficiência de ferro
- Anemia ferropriva
- Dieta pobre em ferro
- Perdas sanguíneas crônicas (menstruação intensa, sangramentos digestivos)
- Má absorção intestinal
Esse achado é muito comum em fases iniciais da deficiência de ferro, mesmo antes do surgimento de sintomas mais evidentes, como os descritos em casos de sintomas de ferro baixo.
Transferrina alta: quando acontece
A siderofilina tende a aumentar quando o organismo percebe que há pouco ferro disponível e tenta compensar produzindo mais proteína transportadora.
As principais causas de transferrina alta são:
- Deficiência de ferro
- Anemia ferropriva
- Gravidez
- Uso de anticoncepcionais
- Dieta pobre em ferro
Nesse cenário, o corpo “produz mais caminhões” para tentar transportar um ferro que está em falta.
Transferrina baixa: o que pode indicar
A transferrina baixa geralmente não está relacionada à falta de ferro, mas a condições que reduzem sua produção ou alteram o metabolismo proteico.
As causas mais comuns incluem:
- Doenças inflamatórias crônicas
- Infecções
- Doenças hepáticas
- Desnutrição
- Doenças crônicas avançadas
Em muitos casos, a siderofilina baixa ocorre junto com ferritina normal ou elevada, o que pode confundir a interpretação sem uma análise clínica adequada.
Transferrina baixa significa ferro alto?
Não necessariamente.
Em situações de inflamação, por exemplo, o organismo reduz a produção dessa proteína como mecanismo de defesa, enquanto a ferritina pode aumentar. Isso não significa excesso saudável de ferro, mas sim uma alteração do metabolismo relacionada à inflamação.
Por isso, transferrina, ferritina e índice de saturação devem sempre ser avaliados em conjunto.
O metabolismo do ferro no organismo
O ferro é um micronutriente essencial para diversas funções vitais, especialmente para a produção de glóbulos vermelhos e o transporte adequado de oxigênio pelo corpo. Para que esse mineral seja aproveitado corretamente, o organismo depende de um sistema integrado que envolve absorção intestinal, transporte no sangue, armazenamento e utilização celular.
Alterações nesse equilíbrio podem ocorrer mesmo quando os níveis de ferro parecem normais em exames isolados. Processos inflamatórios, infecções, doenças crônicas, alterações hepáticas e deficiências nutricionais podem interferir diretamente na forma como o ferro é distribuído e utilizado, levando a sintomas como cansaço persistente, fraqueza, dificuldade de concentração e queda de desempenho físico.
Por esse motivo, a avaliação do metabolismo do ferro deve sempre considerar um conjunto de marcadores laboratoriais, e não apenas um único exame. A análise integrada permite identificar precocemente desequilíbrios que, se não investigados, podem evoluir para quadros de anemia ou comprometer o bem-estar a médio e longo prazo.
Quando investigar melhor as alterações da transferrina
É recomendado aprofundar a investigação quando:
- Há sintomas como cansaço excessivo, fraqueza ou palidez
- O hemograma apresenta alterações persistentes
- Existe histórico de anemia recorrente
- A ferritina não explica os sintomas
- O índice de saturação da transferrina está baixo ou elevado
Nesses casos, exames complementares para detectar anemia podem ser necessários para identificar a causa real do problema.
Preparo para o exame de transferrina
O exame é realizado por coleta de sangue venoso.
Orientações gerais:
- Jejum não necessário
- Informar uso de suplementos de ferro ou medicamentos
- Evitar esforço físico intenso antes da coleta
FAQ – Dúvidas frequentes sobre transferrina
1. Transferrina alta significa anemia?
Nem sempre, mas é um achado comum na anemia por deficiência de ferro, especialmente nas fases iniciais.
2. Índice de saturação da transferrina baixo é grave?
Depende da causa. Pode indicar deficiência de ferro que precisa ser investigada e tratada, principalmente se houver sintomas.
3. Ferritina normal descarta problema no ferro?
Não. É possível ter ferritina normal e ainda assim apresentar deficiência funcional de ferro.
4. Siderofilina baixa pode indicar inflamação?
Sim. Doenças inflamatórias e infecções podem reduzir a produção de transferrina.
5. Precisa de pedido médico para fazer o exame de metabolismo do ferro?
Em geral, não. O exame pode ser realizado de forma particular, mas a interpretação deve sempre considerar avaliação clínica.
Onde realizar o exames de metabolismo do ferro com preço acessível
Realizar o exame em um laboratório especializado faz diferença na qualidade do resultado e na interpretação correta dos achados.
No Posenato Diagnósticos, você conta com:
- Atendimento particular e humanizado
- Orientação clara sobre preparo e resultados
- Estrutura técnica confiável
- Integração com outros exames do metabolismo do ferro
Agende seu exame de transferrina no Posenato Diagnósticos e cuide da sua saúde com economia e segurança.
A realização e interpretação dos exames não substituem a avaliação médica.
Referência:
Deficiência de ferro – Manual MSD
Anemia em adultos: uma abordagem contemporânea para o diagnóstico.